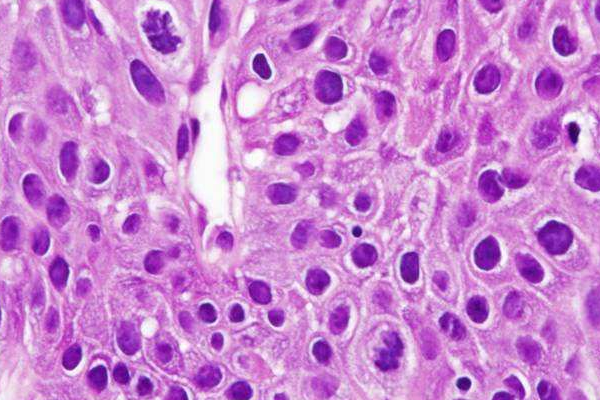

什么是核分裂象?定义是什么?跟病理性核分裂象的关系
核分裂象是指细胞分散均匀,数量也多。有较多数量的间期核意味着细胞培养成功。肿瘤细胞核分裂象多见,并有病理性分裂象。核膜消失,核染色质聚集,边缘呈锯齿状。
在恶性肿瘤细胞中,细胞在分裂过程中,染色体可分为多极,如3极、4极、5极甚至更多不规则的形态,这样就使一个瘤细胞在分裂时可分为3个、4个、5个或更多细胞,故恶性肿瘤生长较快。
扩展资料
核分裂以典型、核呈丝状分裂状态的正常及病理性核分裂象为准计数;异型性指细胞核特点,表现为核大、大小不一、浓染、染色质粗、核膜厚、核形状不规、核仁大、清楚等。以石蜡切片观察核分裂象的数目作为主要依据:
①每个高倍镜视野下核分裂象多于2个则为恶性;
②每10个高倍镜视野下核分裂象超过5个为肉瘤;
③每25个高倍镜视野下核分裂象为1~5个为低度恶性,多于5个为肉瘤;
④镜下有不典型核分裂象,核的多形性和染色深是肉瘤的基本特征;
⑤每25个高倍镜视野下核分裂象数4个,圆形核超过20%为肉瘤。
参考资料来源:百度百科-核分裂象增多
参考资料来源:百度百科-分裂象
声明:本网站引用、摘录或转载内容仅供网站访问者交流或参考,不代表本站立场,如存在版权或非法内容,请联系站长删除,联系邮箱:site.kefu@qq.com。
阅读量:91
阅读量:99
阅读量:139
阅读量:96
阅读量:74